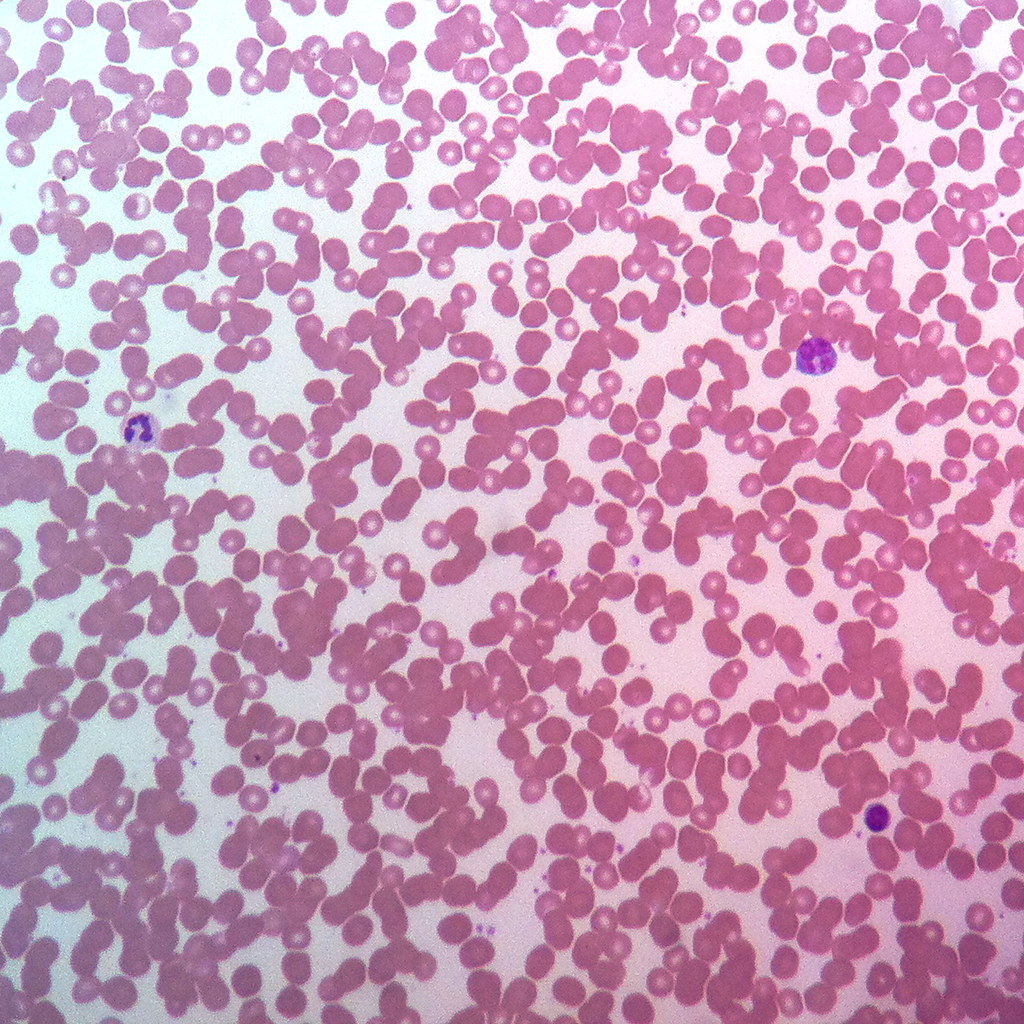
term image

1/47
Looks like no tags are added yet.
Name | Mastery | Learn | Test | Matching | Spaced |
|---|
No study sessions yet.

loose adipose connective tissue

loose areolar connective tissue

reticular fibers

dense regular connective tissue

dense irregular connective tissue

elastic dense connective tissue
location of areolar loose connective tissue
dermis
location of adipose loose connective tissue
kidney
location of reticular loose connective tissue
kidney
location of dense regular connective tissue
tendon
location of dense irregular connective tissue
dermis
location of elastic dense connective tissue
spinal column

hyaline cartilage solid connective tissue

elastic cartilage solid connective tissue

fibrocartilage solid connective tissue
location of hyaline cartilage solid connective tissue
ribs
location of elastic cartilage solid connective tissue
epiglottis
location of fibrocartilage
pads within knee joint
example of embryonic connective tissue
mesenchyme

compact bone
location of compact bone
bone marrow
location of blood
blood vessels
blood fluid connective tissue
location of lymph fluid connective tissue
lymphatic vessels
whats another name for red blood cells
erythrocytes
whats another name for white blood cells
leukocytes
what are three types of fluid connective tissues
erythrocytes, leukocytes, platelets
what are examples of neural tissues
neuroglia and neuron
where are the neuroglia and neuron
brain

skeletal muscle tissue

cardiac muscle tissue

smooth muscle tissue
location of smooth muscle tissue
blood vessels
location of cardiac muscle tissue
heart
location of skeletal muscle tissue
tendons
what kind of fibers are straight, unbranched, and not flexible
collagen fibers
what kind of fibers are branched, multi-directional, and look like a net
reticular fibers
what kind of fibers are branched, wavy, and look like a bungie cord
elastic fibers
what kind of tissue is mesenchyme
embryonic connective tissue
what loose connective tissue are the protein fibers a part of
areolar

1
cell body

4
axon

5
dendrites

6
neuroglia

1
neurons

left
elastic fiber

collagen fibers

reticular loose connective tissue